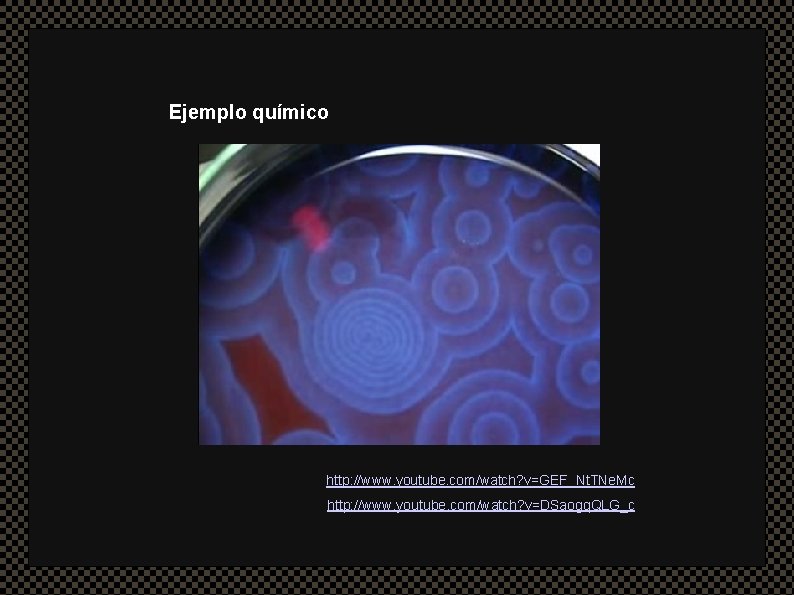
Ejemplo químico http: //www. youtube. com/watch? v=GEF_Nt. TNe. Mc http: //www. youtube. com/watch? v=DSaogq.

Complejidad Vida creacin y cognicin ms all de













































- Slides: 45

Complejidad Vida, creación y cognición más allá de la mente Sistemas de elementos interrelacionados y en interacción, con propiedades: emergentes, no presentes en cada uno de los elementos generativas, capaces de construir orden desde el desorden

http: //www. youtube. com/watch? v=KPP-4 -LEHXQ

http: //www. youtube. com/watch? v=vyo 38 P 6 NBRE http: //www. youtube. com/watch? v=wqy. Nbl. Lj. I 60&NR=1
Ejemplo químico http: //www. youtube. com/watch? v=GEF_Nt. TNe. Mc http: //www. youtube. com/watch? v=DSaogq. QLG_c

Wayne Levin, Fish Schools fuente: doraballa-ommo. blogspot. com

Wayne Levin, Fish Schools fuente: doraballa-ommo. blogspot. com

Antony Gormley, Block Works (2004) http: //www. artium. org/expo_between. html

Quantum Void (2008) Quantum Cloud XXIII (2000) Antony Gormley

Entre otras cosas. . . Fin del mito sobre la singularidad de - la creación e invención - la vida - la cognición como ‘dones’ específicos sin origen material Cambio cultural, no se trata de una 'revolución' científica solamente

Desmitificación de la ciencia / producción de valor Galileo Justus Sustermans (1636) Rembrandt Tobías devuelve la vista a su padre (1636)

El punto de vista de la física La termodinámica protagonista de los inicios de la complejidad. la ciencia de los procesos Dos principios, a finales del s. XIX - La energía total es constante - Crecimiento de la entropía en sistemas cerrados

Movement of a Moment (2005) Keiji Kawashima Between Order and Chaos (2004) http: //www. salvadordiaz. net/VENTILADORES. swf

Ludwig Boltzmann y la mecanización de la termodinámica estadística, poblaciones, complexiones Experimento mecánico temperatura pelotas http: //www. youtube. com/watch? v=Xgi-Da 28 Py 4

Movimiento browniano: difusión de un mosquito, movimiento de un grano de polen en el agua, oscilaciones alrededor del equilibrio de la Bolsa. . . http: //www. youtube. com/watch? v=anl. Ve_7 W 3 T 0 http: //www. youtube. com/watch? v=i. B 7 Eu 7 U 73 qg http: //www. youtube. com/watch? v=6 Vd. Mp 46 ZIL 8 Fluctuaciones. . . ergodicidad. . . indeterminismo. . . Smoluchowski, Ehrenfest, Schweidler

Bases físicas y químicas de la vida Erwin Schrödinger, ¿Qué es la vida? Metabolismo : Decrecimiento de la entropía Poiesis en los procesos fuera del equilibrio Ilya Prigogine, carácter constructivo de los procesos fuera del equilibrio. Materia que deja de estar ciega. (nuevo escenario de relación con los procesos)

Objetos de intercambio El giro tecnocientífico - Big Science Laboratorios a gran escala - conflicto entre las culturas de las disciplinas: zonas de intercambio (trading zones), lenguajes criollos, objetos frontera (boundary objets) Edward Lorenz (Los Alamos) y el efecto mariposa, Mandelbrot y los fractales. Computación: capacidad de simulación de procesos y de cambio de escala.

Contextos de aplicación - Mesh, Redes Sociales, Web 2. 0 - Copyleft, Open Source - Sistemas dinámicos, sistemas complejos -?

Stanisław Lem (1972) Daniel Silvo Technoaceitunas (2002) http: //vimeo. com/2562182

Procesos, código, iteración Tres casos distintos de Emergencia Combinatoria – Complexiones Agregación de procesos, multiplicidad, azar y percolación Sistemas L Fractales Estructuras disipativas o vibraciones? Autómatas celulares Vida artificial Inteligencia artificial, redes neuronales

Tres casos distintos de Emergencia Luci (2007 - ) J. M. Berenguer http: //www. sonoscop. net/jmb/lucy/index. html

Tres casos distintos de Emergencia Urban Mobs (2008) http: //www. urbanmobs. fr/en/

Tres casos distintos de Emergencia Zexe. net Antoni Abad http: //www. zexe. net

Combinatoria – complexiones - Escala Fractal Invader (2003) Jared Tarbell http: //complexification. net/gallery/machines/invaderfractal/ MORPHOcarrots Morphotheque # 9, (1997) Driessens & Verstappen http: //www. xs 4 all. nl/~notnot/morpho/MORPHOcarrots. html

Exactitudes Ari Versluis and Ellie Uyttenbroek http: //www. exactitudes. com/ The Sheep Market Aaron Koblin http: //www. thesheepmarket. com Todas las historias, Lo posible Dora García http: //doragarcia. net/insertos

Agregación de procesos, azar y percolación Process #4 Casey Reas http: //www. reas. com/iperimage. php? section=works&view=&work=p 4_s&id=0 http: //www. reas. com/iperimage. php? section=works&view=&work=p 4_formdata_p&id=0 http: //www. reas. com/texts/processcompendium. html

Agregación de procesos, azar y percolación Visualizaciones del azar galaxias, percolación (contagios, etc) Deterministic Nonperiodic Flow (1963) Eva Schindling / Daniel J. Wilson http: //dnf. evsc. net/

Sistemas L (Lindenmayer) Curva de Koch http: //www. noviembre. org/abe/koch Generación de árboles http: //www. noviembre. org/abe/arbol

Tree Garden Jared Tarbell http: //complexification. net/gallery/machines/tree. Garden/ Substrate (2003) Jared Tarbell http: //www. complexification. net/gallery/machines/substrate/

Karl Sims Aesthetic Evolutionary Algorithm (1991) . walk! Social Fiction http: //www. socialfiction. org/dotwalk/dummies. html

Fractales Gestalt (2003) Thorsten Fleisch http: //fleischfilm. com/? cat=4 African fractals Ron Eglash http: //128. 113. 2. 9/~eglash/eglash. htm

Estructuras disipativas Decryptopattern Daisuke Ishida + Noriko Yamaguchi http: //decryptopattern. com/

Estructuras disipativas Cara Barer http: //www. carabarer. com/portfolio/2006 -2007/

Autómatas celulares Explicación. A New Kind of Science (simulación partículas, galaxias, etc. ) Game of Life John Conway http: //www. noviembre. org/abe/gameoflife LA. 2 Kenta Cho http: //www. asahi-net. or. jp/~cs 8 k-cyu/flash/la 2/ http: //www. youtube. com/watch? v=0 eo 0 z. G-d. Tw. E

Juego del Go E-volver Driessens & Verstoppen http: //www. xs 4 all. nl/~notnot/E-volver. LUMC. html http: //www. xs 4 all. nl/~notnot/evolvedxxw_youtube. html

Vida Artificial Life Writer (2006) Christa Sommerer & Laurent Mignonneau http: //www. interface. ufg. ac. at/christa-laurent/WORKS/MOVIES/Life. Writer. Small. mov

Double Helix Swing Ursula Damm http: //ursuladamm. de/category/interactive-installations/double-helix-swing

Small work for robot and insects - 2002 – 2003 Andy Gracie http: //www. hostprods. net/projects/small-work-for-robot-and-insects/

Inteligencia Artificial Rechnender Raum / Calculating Space Ralf Baecker http: //www. no-surprises. de/rechnender_raum

Parasitic Computing Albert-Laszlo Barabasi http: //www. nd. edu/~parasite/

BCC Platoniq http: //www. bancocomun. org/

Performative ecologies (2008) Ruairi Glynn http: //www. fundacion. telefonica. com/arteytecnologia/certamen_vida/ediciones/vida 11/performative_ecologies. htm Audience (2008) r. Andom International http: //www. random-international. com/news/2008/10/23/audience-at-the-royal-opera-house. html

Trace. Encounters (2004) W. Bradford Paley and Jefferson Y. Han http: //www. traceencounters. org/index. html

Cuerpo Red Biophil Mark Cypher http: //wwwmcc. murdoch. edu. au/multimedia/mark/biophil 2. htm

Blu Walls BLU http: //www. blublu. org

Quino de la colección Potentes, prepotentes, impotentes